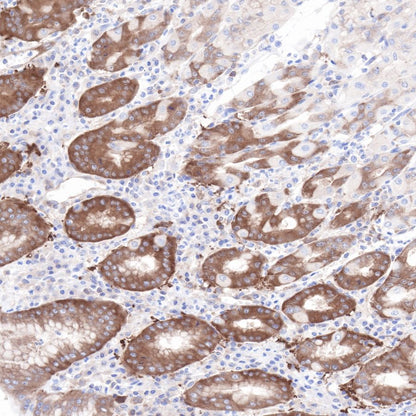
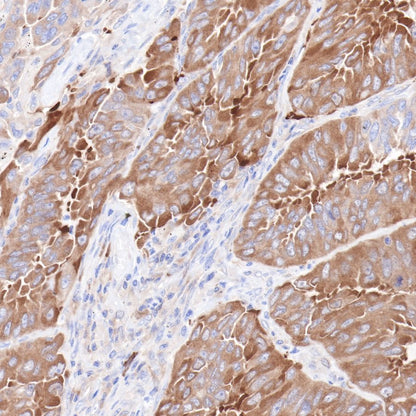
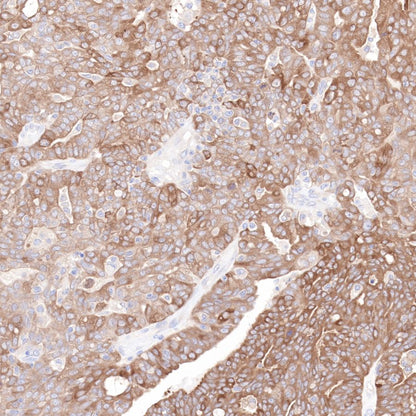

Product Specification
| Host |
Rabbit |
| Antigen |
Hsp90 beta |
| Synonyms |
HSP90B, HSPC2, HSPCB,HSP90AB1 |
| Immunogen |
Synthetic Peptide |
| Location |
Cytoplasm, Nucleus, Secreted, Membrane |
| Accession |
P08238 |
| Clone Number |
SDT-R033 |
| Antibody Type |
Rabbit mAb |
| Application |
WB, IHC-P, ICC, ICFCM, IP |
| Reactivity |
Hu, Ms, Rt |
| Purification |
Protein A |
| Concentration |
0.5 mg/ml |
| Physical Appearance |
Liquid |
| Storage Buffer |
PBS, 40% Glycerol, 0.05%BSA, 0.03% Proclin 300 |
| Stability & Storage |
12 months from date of receipt / reconstitution, -20 °C as supplied |
Dilution
| application |
dilution |
species |
| IP |
1:25 |
|
| IHC-P |
1:2000 |
|
| WB |
1:1000 |
|
| ICFCM |
1:500 |
|
| ICC |
1:500 |
|
Background
Heat shock protein HSP 90-beta also called HSP90beta is a protein that in humans is encoded by the HSP90AB1 gene. HSP90AB1 is a molecular chaperone. Chaperones are proteins that bind to other proteins, thereby stabilizing them in an ATP-dependent manner. Chaperones stabilize new proteins during translation, mature proteins which are partially unstable but also proteins that have become partially denatured due to various kinds of cellular stress. In case proper folding or refolding is impossible, HSPs mediate protein degradation. They also have specialized functions, such as intracellular transport into organelles. HSP90AB1 and its co-chaperones are frequently overexpressed in cancer cells. They are able to stabilize mutant proteins thereby allowing survival and increased proliferation of cancer cells. This renders HSPs potential targets for cancer treatment. In salivary gland tumors, expression of HSP90AA1 and HSP90AB1 correlates with malignancy, proliferation and metastasis. The same is basically true for lung cancers where a correlation with survival was found.